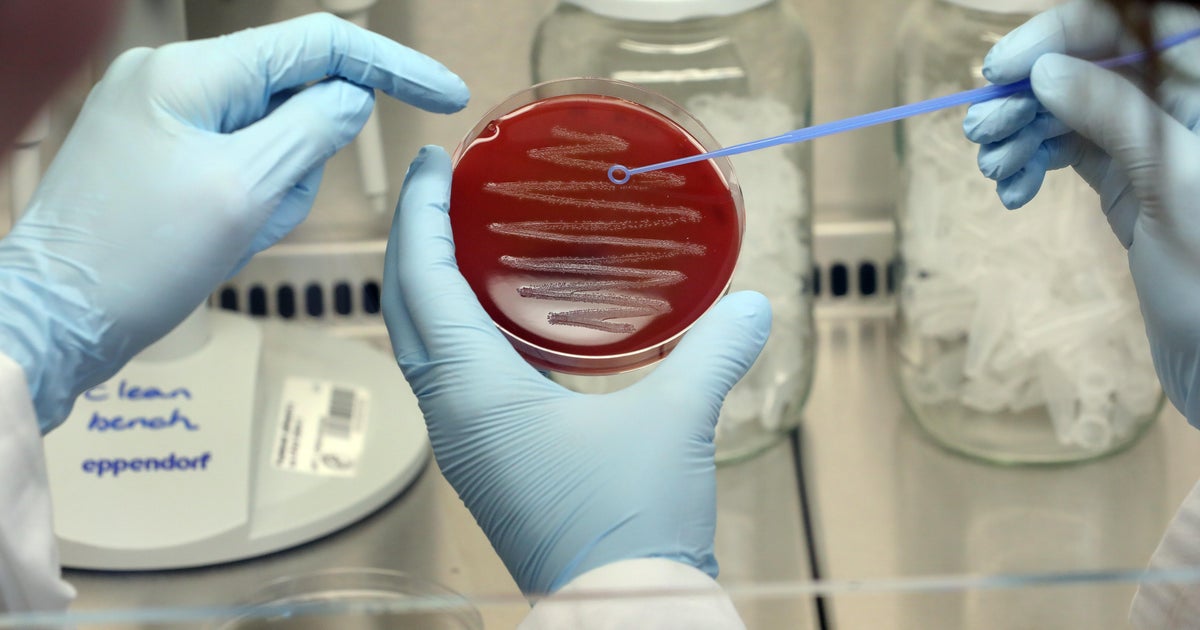
A deadly bacterial infection is spreading in Japan. Here’s what to know about causes and prevention. A deadly bacterial infection is spreading in Japan. Here’s what to know about causes and prevention.

A potentially deadly bacterial infection called streptococcal toxic shock syndrome, or STSS, is spreading in Japan, prompting questions about what causes it and how to prevent it.
Japan’s National Institute of Infectious Diseases issued a statement in March warning that STSS was increasing in the country. As of June 2, Japan’s health ministry reports 977 cases since the start of 2024 — surpassing last year’s 941 cases.
That’s almost two and a half times the number reported in the U.S. so far this year.
STSS is a “rare, but serious” bacterial infection that can “develop very quickly into a life-threatening emergency,” according to the Centers for Disease Control and Prevention.
First symptoms of STSS often include fever, chills, muscle aches, nausea and vomiting, the CDC states. Japan’s health ministry adds people also experience pain and swelling in the arms and legs.
After 24 to 48 hours, low blood pressure typically develops and can cause more serious issues, including organ failure, increased heart rate and rapid breathing.
“Even with treatment, STSS can be deadly. Out of 10 people with STSS, as many as 3 people will die from the infection,” the CDC says.
In the U.S., the CDC has tallied 395 cases reported so far this year, not far off from the 390 reported at this time last year.
What causes streptococcal toxic shock syndrome?
STSS is caused by toxins released by Streptococcus pyogenes, also known as Group A Streptococcus, or GAS, which commonly cause sore throat and skin infections, explains Dr. Céline Gounder, a CBS News medical contributor, infectious diseases expert and editor-at-large for public health at KFF Health News.
“Less commonly, GAS causes infection in the blood, lungs, as well as ‘flesh-eating’ infections,” Gounder explained. “Approximately 30 to 60% of people experiencing these most serious infections will die from them.”
It is not yet understood why these severe infections are becoming more common, experts say, but there are ways to help prevent infection.
“Because chickenpox and influenza are risk factors for severe GAS infection, vaccination against varicella zoster virus and influenza can reduce the risk of severe GAS infection,” Gounder said. “People who have been in close contact with someone with severe GAS infections and who are immunocompromised, pregnant, or have open wounds should be given antibiotics to prevent infection.”
Where is SSTS found?
Anyone can get STSS, the CDC says, but certain risk factors can increase your risk, including:
- Age — it’s most common in adults 65 or older
- Infections or injuries that break the skin
- Other health factors, including diabetes and alcohol use disorder
Risk factors for severe Group A Streptococcus infections, Gounder said, include trauma, surgery, burns, immunosuppression, pregnancy, diabetes, injection drug use, homelessness, and chickenpox or influenza infection.
Since late 2022, multiple countries have experienced increasing rates of GAS, including the United Kingdom, Ireland, France, the Netherlands and Sweden.
“Outbreaks like these speak to the need for ongoing infectious disease surveillance and control, not only in the United States, but around the world,” Gounder said.
link